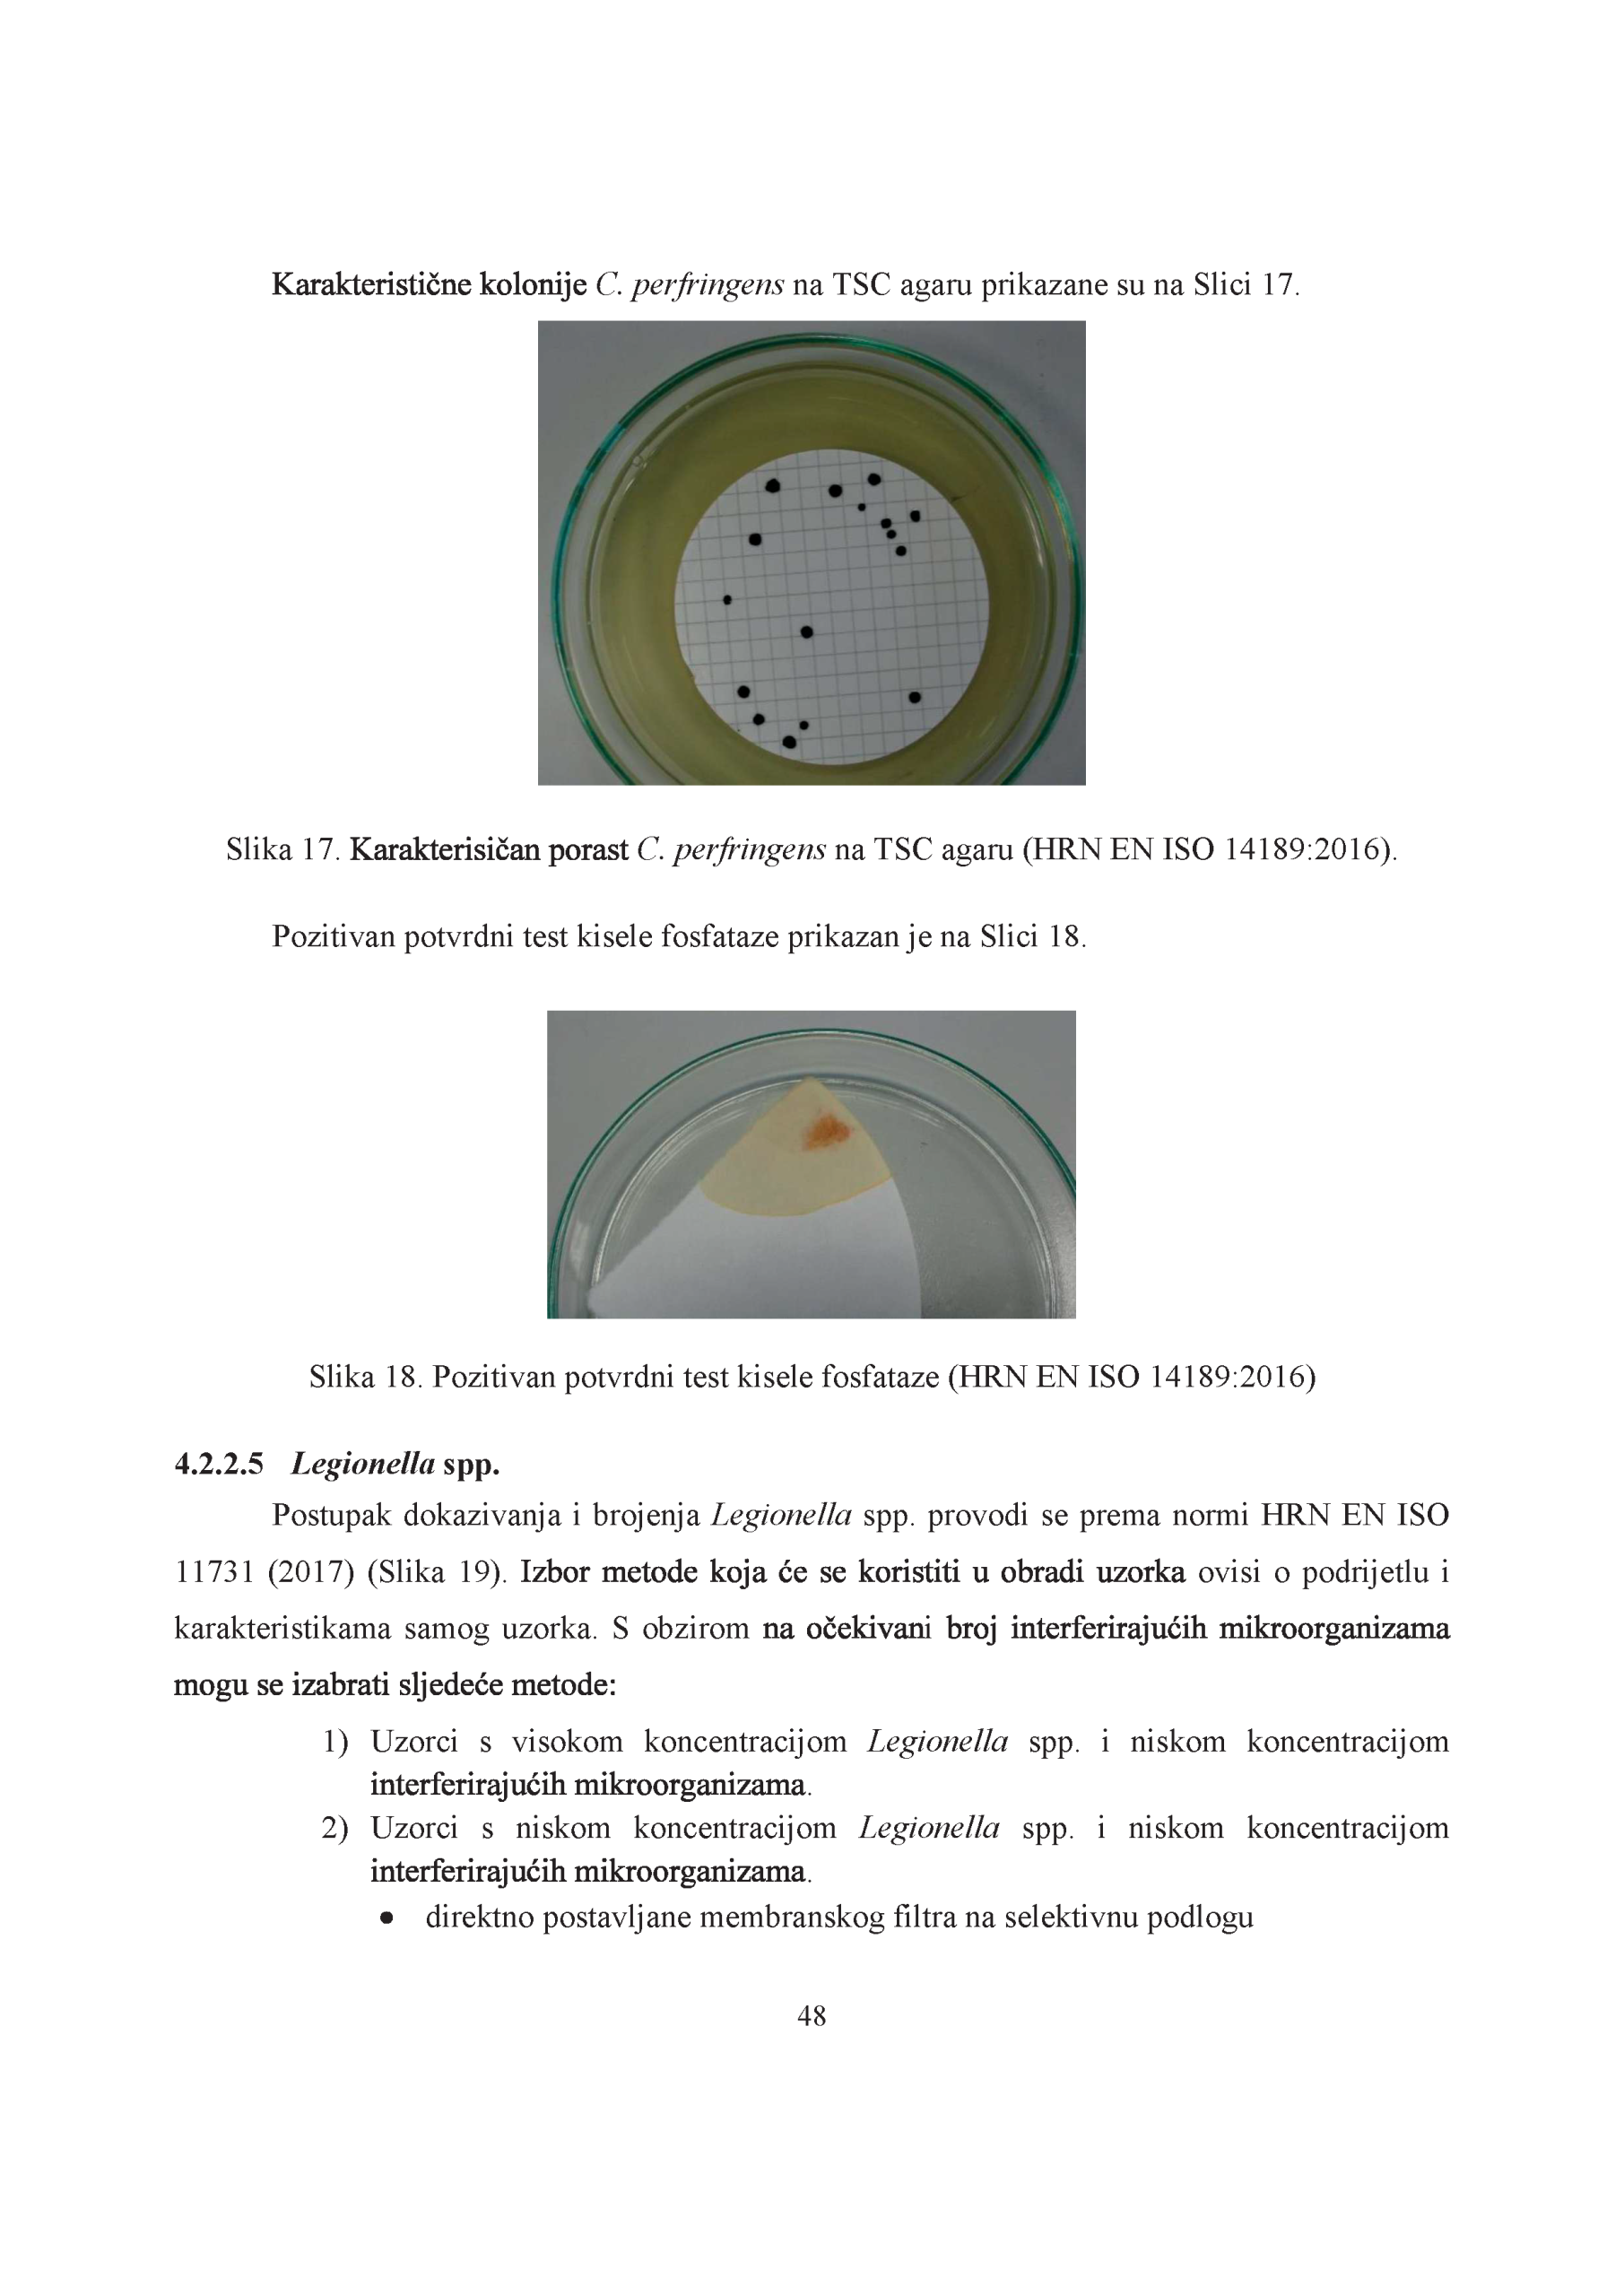

Urednica:
- prof. dr. sc. Marina Šantić
Autori:
- prof. dr. sc. Marina Šantić,
- prof. dr. sc. Ivana Gobin,
- prof. dr. sc. Darija Vukić-Lušić, i
- dr. sc. biomed. Maša Antonić
- dr. sc. Ina Viduka
Sažetak:
Priručnik Mikrobiologija vode namijenjen je studentima prijediplomskog studija Sanitarnog inženjerstva kao vodič za razumijevanje i primjenu mikrobioloških metoda u kontroli zdravstvene ispravnosti vode. Obrađuje pravila sigurnog rada u mikrobiološkom laboratoriju, osnove mikroskopije te ključne tehnike analize i dokazivanja prisutnosti mikroorganizama. Poseban naglasak stavlja na mikrobiološku kontrolu različitih vrsta voda, uključujući vodu za piće, bazensku i morsku vodu, prirodne mineralne vode te vodu za hemodijalizu.
Priručnik objašnjava normirane metode uzorkovanja i analize, poput tehnike membranske filtracije, uz detaljne upute za detekciju specifičnih mikroorganizama kao što su E. coli, koliformne bakterije, enterokoki, Pseudomonas aeruginosa, Legionella spp., enterični virusi i paraziti. Također, uključuje suvremene molekularne metode analize, omogućujući studentima stjecanje praktičnih i teorijskih kompetencija za profesionalni rad u području sanitarne mikrobiologije.
Svrha priručnika Mikrobiologija vode je omogućiti studentima prijediplomskog studija Sanitarnog inženjerstva stjecanje teorijskih znanja i praktičnih vještina za mikrobiološku analizu i kontrolu zdravstvene ispravnosti vode u skladu s normiranim metodama i standardima.
Iz recenzija:
” … Objava djela je od neprocjenjivog značaja za obrazovanje budućih sanitarnih inženjera. Ne postoje djela sličnog sadržaja i kakvoće. Djelo u potpunosti prati nastavni plan i metodički je prilagođeno za kolegij “Mikrobiologija vode” koji se održava na trećoj godini prijediplomskog studija sanitarnog inženjerstva na Medicinskom fakultetu Sveučilišta u Rijeci. Autori su koristili relevantnu literaturu kako bi studentima omogućili temeljitije proučavanje svih tema. Terminologija, metode i mjerne jedinice usklađeni su s važećim propisima i praksama. … ” dr. sc. Damir Kapetanović
” …. Priručnik Mikrobiologija vode predstavlja prerađeno i ažurirana izdanje namijenjena studentima Sveučilišnog prijediplomskog studija sanitarnog inženjerstva. Kao znanstveno i stručno relevantan nastavni materijal, priručnik je u potpunosti usklađen s aktualnim ISO standardima. …” doc. dr. sc. Arijana Cenov
” …. Djelo ispunjava zznačajan društveni interes, s obzirom na rastuću potrebu za stručnim literaturama o kvaliteti vode i javnom zdravlju. Njegova relevantnost dodatno je naglašena nedostatkom suvremenih tekstova na hrvatskome jeziku o ovoj specifičnoj temi. ….” izv. prof. dr. sc. Dijana Tomić Linšak
Fotografije: